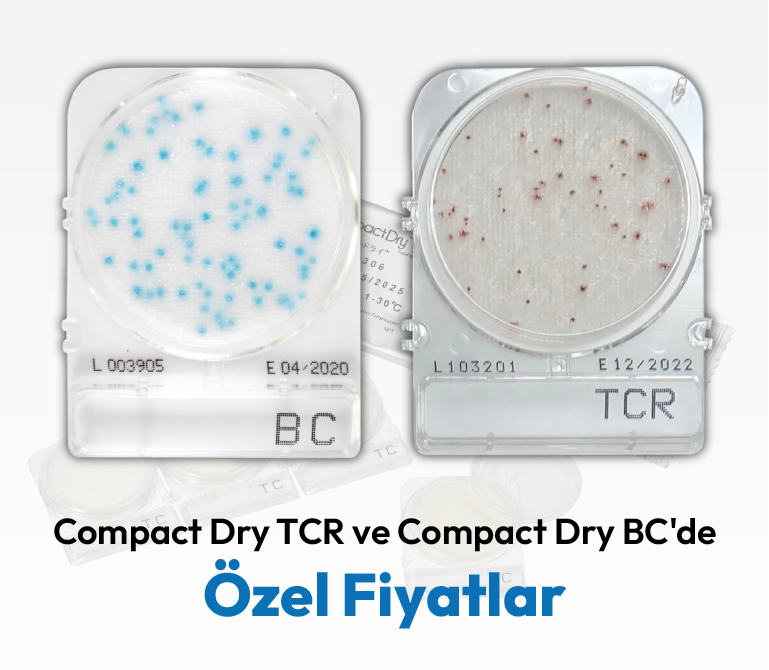

Slide Background

Lumitester Smart
HİJYEN ÖLÇÜMÜNDE A3 TESPİTİ İLE
BAŞKALARININ KAÇIRDIĞINI BULUR
BAŞKALARININ KAÇIRDIĞINI BULUR
ATP+AMP+ADP Hijyen Ölçüm Cihazı
* Cihaz Eğitimi Ücretsizdir.
Slide Background
HFS Slide
Laboratuvar ortamına gerek kalmadan personel, yüzey ve ekipman hijyen performansını güvenilir ve hızlı şekilde ölçen alternatif ve ekonomik bir çözümdür.
Dipslide Besiyeri
Slide Background

Compact Dry
MİKROORGANİZMA, PATOJEN ve
ÖZEL PARAMETRELERİN TESPİTİ İÇİN
ÖZEL PARAMETRELERİN TESPİTİ İÇİN
Kullanıma Hazır Besiyeri
* Mikrobiyoloji Eğitimi ve Danışmanlık Ücretsizdir.
Slide Background

Compact Dry EC
E.coli O157 Tespiti
E.coli O157 Tespiti
Güncellenen Türk Gıda Kodeksi Yönetmeliğine Uygun E.coliO157 Tespiti Yapabilen Kullanıma Hazır Besiyeri
Slide Background
Slide Background

ProCheck &
ProCheck Trace Free
ProCheck Trace Free
İZ BIRAKMADAN PROTEİNLERİ TESPİT EDİN!
Protein Kalıntı Tespit Kiti
Slide Background

Morinaga
Yumurta, Kazein, Gluten, Karabuğday, Fıstık, Soya, Deniz Kabukluları
ALERJEN TEST KİTLERİ